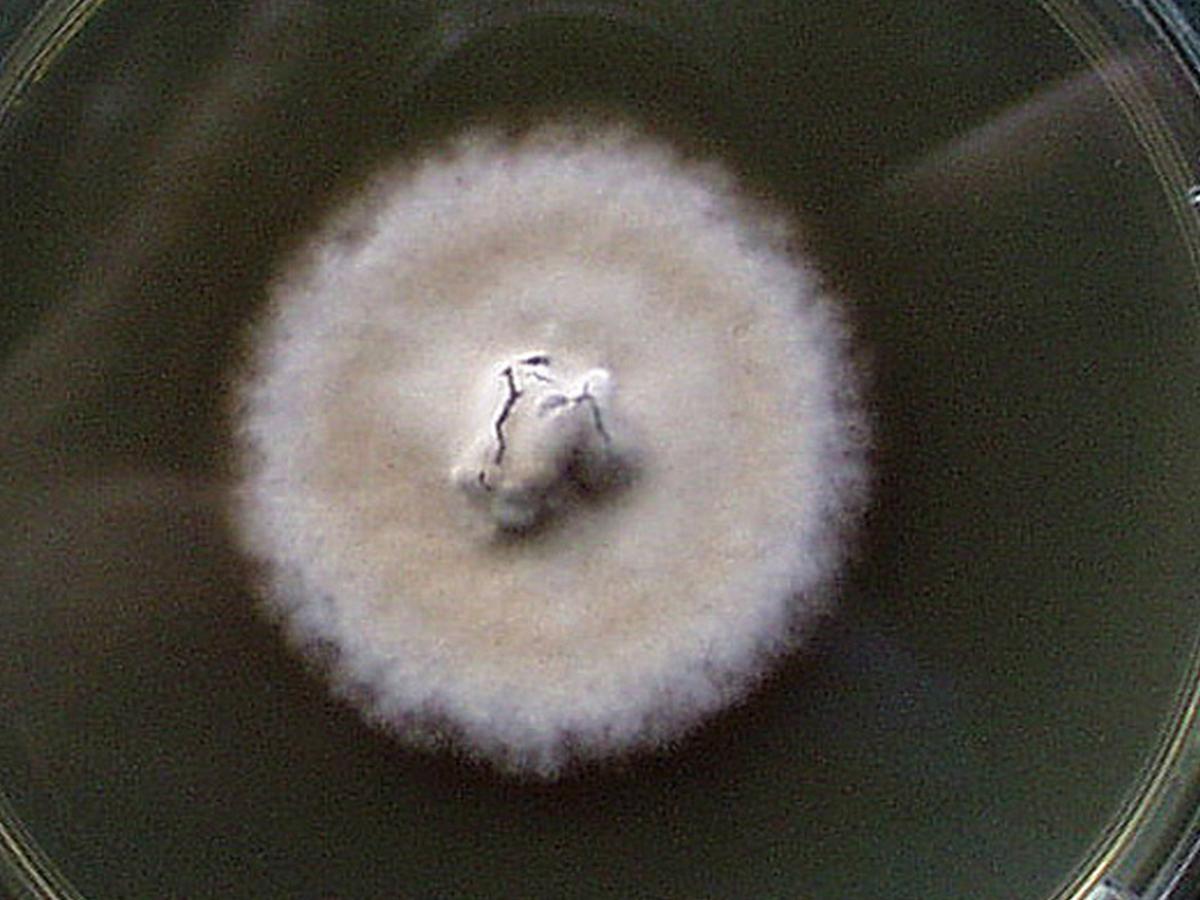
Culture

Status message
Correct! Excellent, you have really done well. Please find additional information below.
Unknown 13 = Histoplasma capsulatum
Direct microscopy (GMS stained tissue section): Tissue morphology of H. capsulatum showing numerous small narrow base budding yeast cells (1-5um diam) inside macrophages.

Culture: On Sabouraud's dextrose agar at 25C, colonies are slow growing, white or buff-brown, suede-like to cottony with a pale yellow-brown reverse. Other colony types are glabrous or verrucose, and a red pigmented strain has been noted.
Microscopy: Microscopic morphology shows the presence of characteristic large (8-14 um in diameter), rounded, single-celled, tuberculate macroconidia formed on short, hyaline, undifferentiated conidiophores. Microconidia, if present, are small (2-4 um in diameter), round to pyriform and borne on short branches or directly on the sides of the hyphae.


Confirmatory exoantigen test: Exoantigen immunodiffusion plate showing positive identification of Histoplasma capsulatum. Note H and M bands of identification; EX = culture filtrate; H = Histoplasma antibody and antigen, C = Coccidioides antibody and antigen; B = Blastomyces antibody and antigen.

Comment: Histoplasmosis is an intracellular mycotic infection of the reticuloendothelial system caused by the inhalation of conidia from the fungus Histoplasma capsulatum. Approximately 95% of cases of histoplasmosis are inapparent, subclinical or benign. Five percent of the cases have chronic progressive lung disease, chronic cutaneous or systemic disease or an acute fulminating fatal systemic disease. All stages of this disease may mimic tuberculosis.
Histoplasma capsulatum has a worldwide distribution, however, the Mississippi-Ohio River Valley in the U.S.A. is recognized as a major endemic region. Environmental isolations of the fungus have been made from soil enriched with excreta from chicken, starlings and bats.
About Histoplasmosis Back to virtual assessment